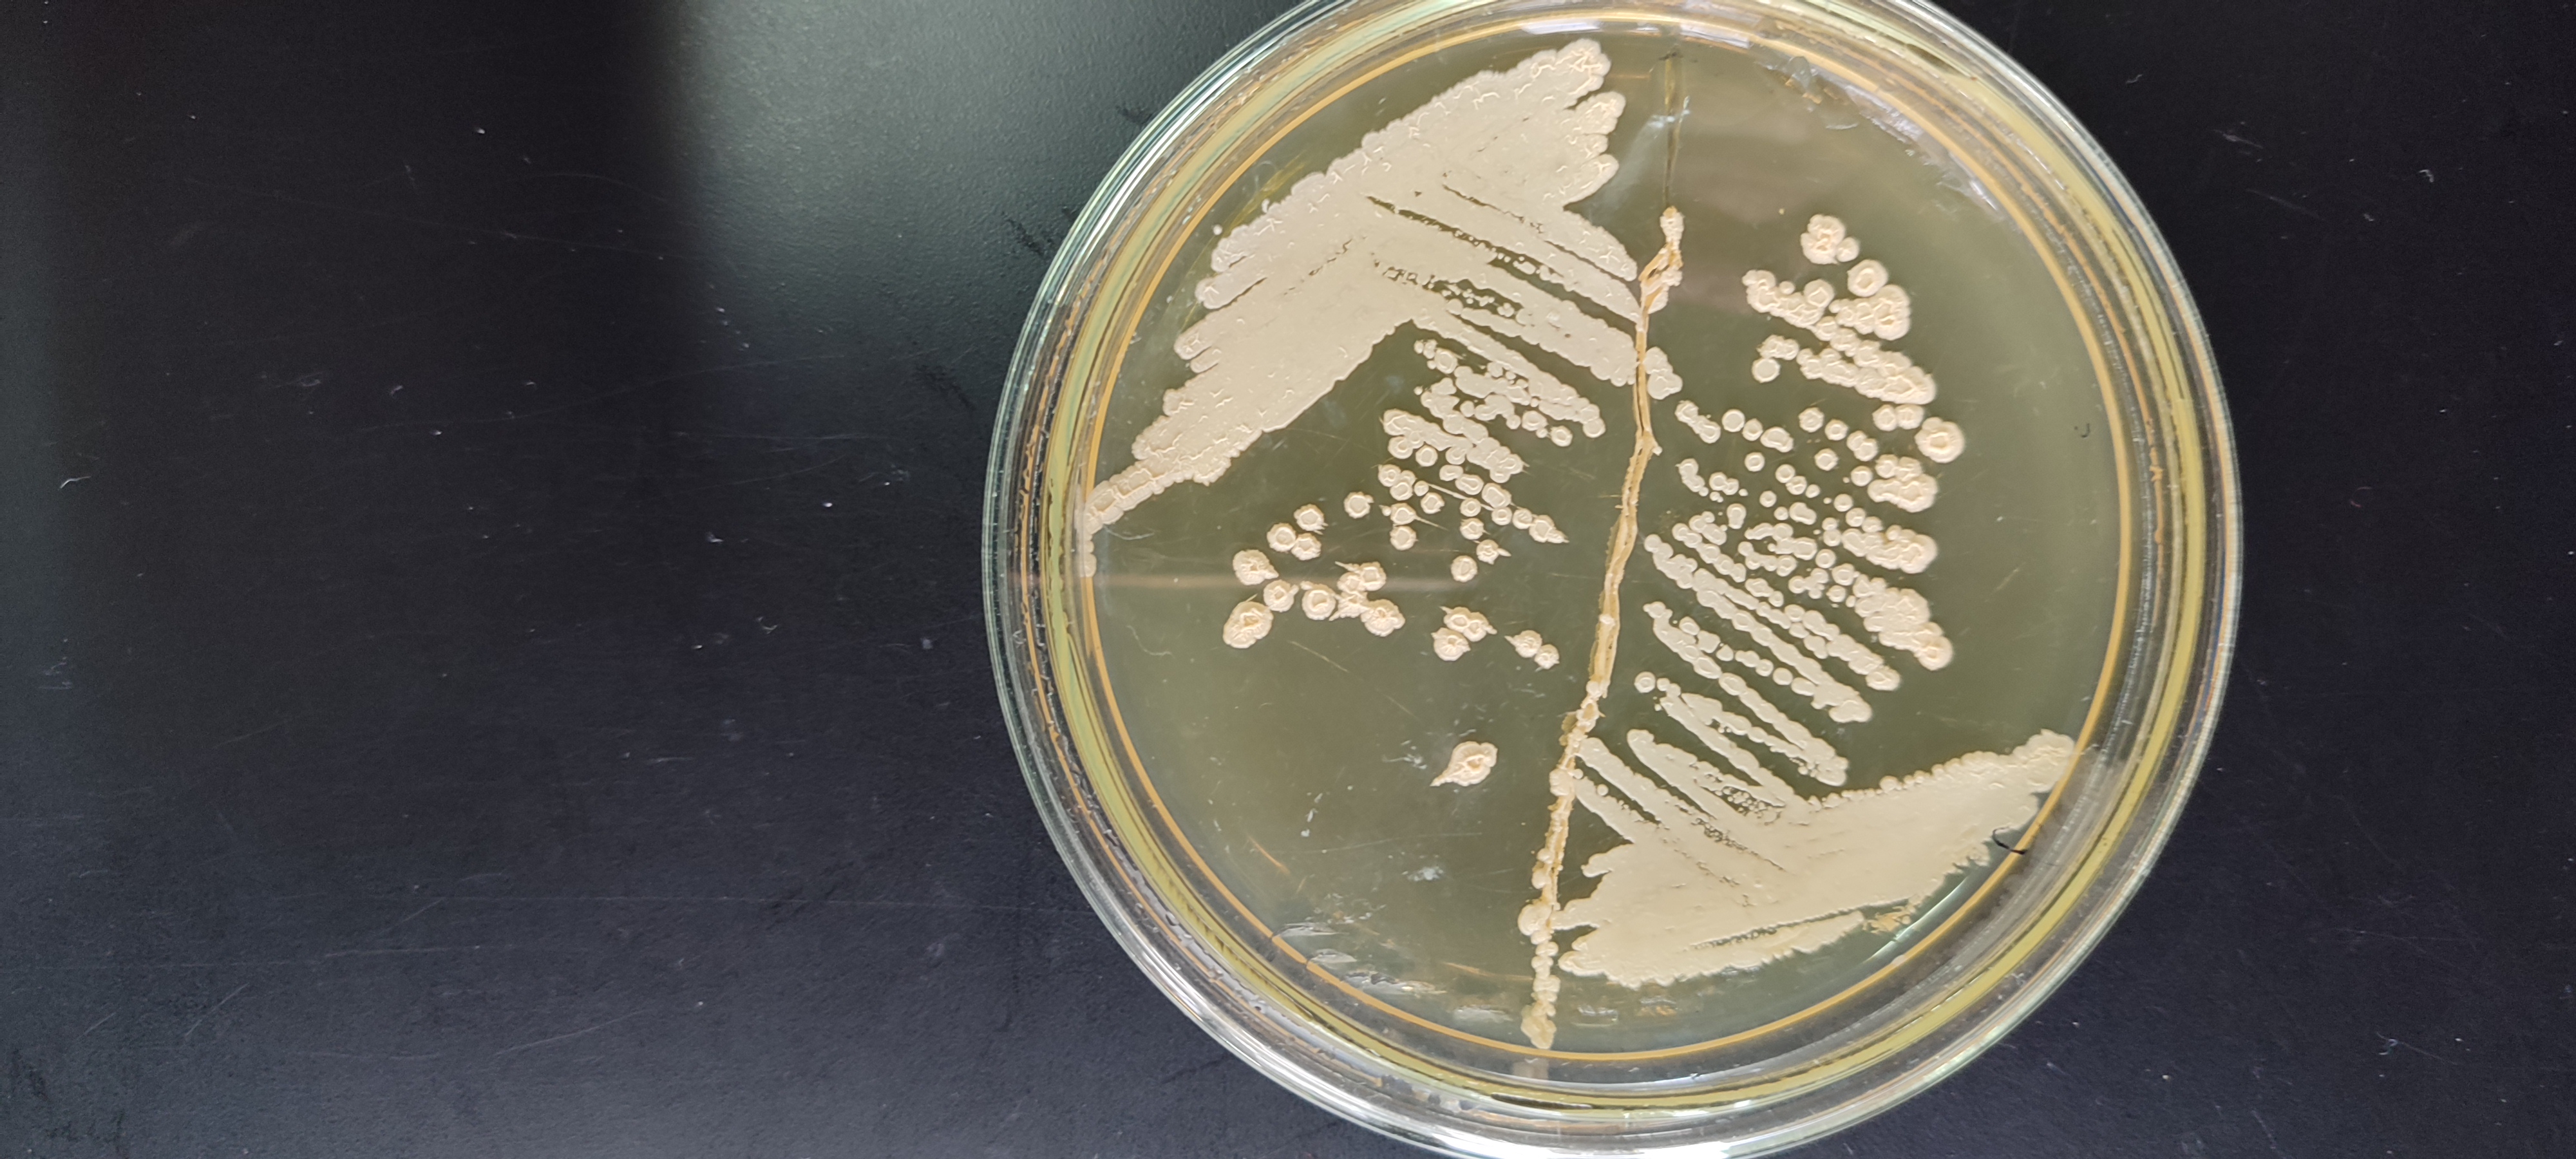
Laboratorio

Cátedra de Química Inorgánica y Analítica - FAUBA
Objetivos
El laboratorio de la Facultad de Agronomía (FAUBA) cuenta con más de 30 años de experiencia en análisis químicos especializados en la caracterización fisicoquímica de sistemas ambientales y agro-productivos.
Ver nuestros objetivos
Líneas de investigación
Desarrollamos proyectos avanzados en química aplicada, enfocados en el estudio y caracterización técnica de suelos, aguas, biomasa y efluentes industriales.
Ver líneas de investigación
Servicios de análisis a terceros
- Análisis fisicoquímicos de suelos y sedimentos.
- Análisis de aguas y efluentes.
- Análisis de biomasa algal y vegetal.

Consultas
Cátedra de Química Inorgánica y Analítica
Pabellón Arata - Facultad de Agronomía (FAUBA)
Av. San Martín 4453, C1417 CABA, Argentina.
Horario de atención: Lunes a viernes de 9 a 16 hs.